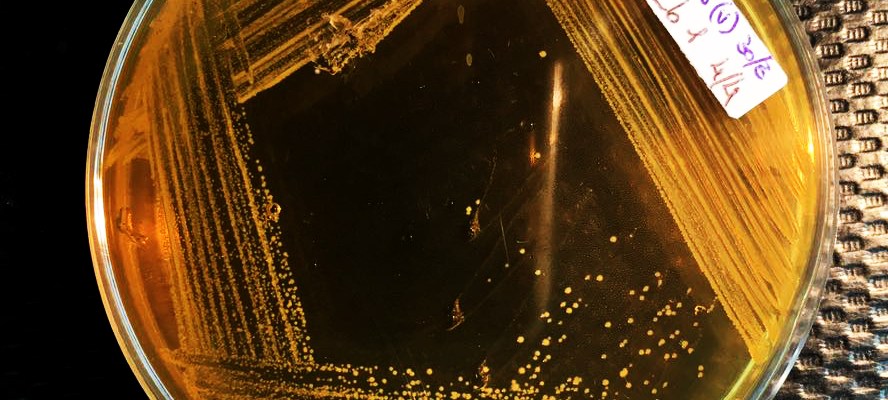

En marzo de este año, defendí la tesis de grado para el título de Veterinario, con el título:
Para ello, realizamos un ensayo con 150 pollitos en INTA Balcarce durante mi residencia (requisito de la carrera que, al igual que la tesis, otras universidades no tienen). El objetivo fue probar la cepa MCY de Lactobacillus reuteri —con habilidades probióticas demostradas in vitro— en pollitos de una línea de carne frente a una infección con Salmonella, en este caso preexistente. Así, se obtuvieron muestras de duodeno para análisis de histomorfometría e histopatología, y muestras de ciego, bazo e hígado para bacteriología y evaluación del efecto (o no) de la cepa sobre la resolución de la infección.
Este ensayo en INTA, al igual que todo lo que se realiza con animales, debió pasar por el comité de bienestar del instituto para su aprobación. La tendencia actual es que en todos los establecimientos los ensayos y trabajos que involucren la utilización y/o experimentación con animales deban ser aprobados por el comité de bienestar de la institución. El bienestar también condiciona los resultados. Y cuando se trata de animales de experimentación, la eutanasia es un tema delicado. De eso hablé en este post; mi conflicto de lo que representaba (y fue) ese momento.
Obtenidas las muestras, las de duodeno fueron procesadas histológicamente y coloreadas con una tinción de rutina. A pesar del esfuerzo, los cortes histológicos no salieron lindos como hubiese querido, pero me permitieron realizar el análisis que necesitaba y escribir la tesis —en fin, era una tesis de grado, no una de doctorado donde se debe ser más científicamente estricto.

Los resultados no fueron alentadores, ya que no observé diferencias en histomorfometría. Pero, como destacó mi director de tesina luego de la defensa, no siempre se observan diferencias significativas en análisis histomorfométricos sin que eso no deje de significar que existe un efecto. Alguna ligera diferencia se vio en lo que fue integridad e infiltrado de la mucosa, y en aislamiento bacteriano de Salmonella en otros órganos, pero no muy concluyente. Tal vez, con un ensayo más prolongado podríamos haber visto mejores resultados.
A pesar que los resultados no fueron los esperados, escribí la tesis lo mejor y más completa que pude, porque me había puesto el objetivo de escribir una tesis de (relativa) buena calidad. Era mi trabajo final de la carrera, quería terminarla como no pude resolverla durante tantos años. Y así fue.
Todo el proceso de residencia y tesis tuvo muchos desafíos para mí. Pero, lo más importante es todo aquello que aprendí. Desde la práctica de realizar ensayos con animales, trabajar los cultivos y aislamientos bacterianos, el muestreo, procesado y análisis histológico, hasta le escritura misma de un texto académico —de gran extensión, para mi director.
El documento final se puede leer en el Repositorio Institucional Digital de la UNICEN http://www.ridaa.unicen.edu.ar/xmlui/handle/123456789/1687.